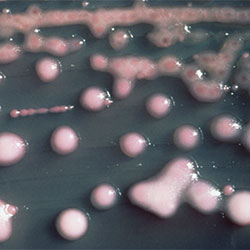

The Infectious Disease Society of America (IDSA) has released its first guidelines for treating complicated urinary tract infections (cUTIs). The guidelines, which build on IDSA’s 2010 recommendations for treating uncomplicated UTIs in premenopausal women, mark a major step to aid clinicians in treating a wider group of people with diverse characteristics.
“In recent years, many randomized control trials for the drugs used to treat cUTIs were released. We were able to use this new evidence to build rigorous guidelines that apply to men and women of all ages. These guidelines are written for the clinicians who most often treat cUTIs in the emergency department, urgent care clinics and hospital wards,” explained guideline author Barbara W. Trautner, MD, PhD, the co-chief of the infectious diseases division at Washington University in Saint Louis, in an interview with Infectious Disease Special Edition.
A 4-Step Process
The guidelines were crafted with the knowledge that changing microbial resistance patterns and the development of new antibiotics mean that creating a static-order list of drugs to use for each pathogen would be inadequate and quickly outdated. Instead, the guidelines are based on a four-step process that considers individual patient characteristics and risk factors for resistance, enabling providers to make evidence-based decisions relevant to the patient in front of them.
The first step in the process calls for a clinician to evaluate how sick a person is and decide whether the patient should be hospitalized for management. The severity of illness (sepsis or no sepsis) determines the group of antibiotics from which clinicians should choose to treat their patient. Second, an antibiotic should be chosen based on a patient’s risk factors for having resistant organisms—previous antibiotic exposure or having had a urine culture with resistant organisms in the past. Third, a clinician should consider each patient’s specific needs, including allergies and the best route of drug administration for that patient.
The fourth step, which only applies to septic patients, is to consult an antibiogram to help guide antibiotic choice. If a patient is in septic shock, and the clinician is using an antibiogram, consider an antibiotic that is likely to cover 90% or more of the most relevant pathogens. If using an antibiogram in a patient with sepsis that has not progressed to shock, choose a suggestion that is likely to cover 80% or more of the most relevant pathogens.
Because there is low mortality in nonseptic cUTIs, there was not enough evidence to model antibiogram use in nonseptic patients.
“Additionally, there were a lot of logistical factors that meant that the antibiogram was a little unwieldy for using with nonseptic patients—without knowing what organism a patient is infected with, it’s pretty hard to apply the antibiogram to empiric antibiotic choice,” Dr. Trautner explained.
Favoring Shorter, Oral Therapy
For nearly all patients, the guidelines recommend using a shorter, rather than a longer, course of antibiotics and switching from IV to oral antibiotics when the patient is improving clinically. However, this recommendation comes with some caveats. The only trials that looked at a five-day treatment course were testing fluoroquinolones, so the recommended treatment duration for non-fluoroquinolone antibiotics is seven days.
In addition, “a longer duration of antibiotics in men with prostatitis may lead to improved outcomes,” Dr. Trautner said. However, she cautioned that physicians don’t necessarily look for prostatitis in men they are treating for cUTIs and that “this is something clinicians should do and is an instance where a shorter duration of antibiotics may not be recommended.”
‘Evidence-Based Direction’
Although he was not associated with developing the guidelines, Thomas M. File Jr., MD, MSc, MACP, FIDSA, FCCP, of the infectious disease division at Summa Health in Akron, Ohio, and a former president of IDSA, noted their publication represents a “major enhancement of our present UTI guidelines, offering evidence-based direction in cases that were not covered by existing uncomplicated, or catheter-associated, UTI treatment guidelines.”
Despite the new and effective tools for treating cUTIs that the guidelines represent, Dr. Trautner cautioned that a subset of the cUTI population suffers from chronic urinary symptoms. “In some cases they experience continuous bladder pain that we may not have solutions for, and it is essential that doctors listen and acknowledge their suffering,” she said. The final section of the guidelines on patient perspectives addresses this issue.
Drs. File and Trautner reported no relevant financial disclosures. Dr. File is a member of the IDSE editorial advisory board.
This article is from the August 2025 print issue.